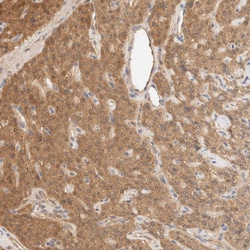
Invitrogen GPI Polyclonal Antibody 100 &mu;L | Buy Online | Invitrogen&trade; | Fisher Scientific

missing translation for 'onlineSavingsMsg'
Learn More
Learn More
Invitrogen™ GPI Polyclonal Antibody
Descrizione
Immunogen sequence: LGIWYINCFG CETHAMLPYD QYLHRFAAYF QQGDMESNGK YITKSGTRVD HQTGPIVWGE PGTNGQHAFY QLIHQGTKMI PCDFLIPVQT Highest antigen sequence indentity to the following orthologs: Mouse - 96%, Rat - 94%.
This gene belongs to the GPI family whose members encode multifunctional phosphoglucose isomerase proteins involved in energy pathways. The protein encoded by this gene is a dimeric enzyme that catalyzes the reversible isomerization of glucose-6-phosphate and fructose-6-phosphate. The protein functions in different capacities inside and outside the cell. In the cytoplasm, the gene product is involved in glycolysis and gluconeogenesis, while outside the cell it functions as a neurotrophic factor for spinal and sensory neurons. Defects in this gene are the cause of nonspherocytic hemolytic anemia and a severe enzyme deficiency can be associated with hydrops fetalis, immediate neonatal death and neurological impairment.

Specifica
Specifica
| Antigene | GPI |
| Applicazioni | Immunohistochemistry (Paraffin), Western Blot, Immunocytochemistry |
| Classificazione | Polyclonal |
| Concentrazione | 0.1 mg/mL |
| Coniugato | Unconjugated |
| Formulazione | PBS with 40% glycerol and 0.02% sodium azide; pH 7.2 |
| Gene | GPI |
| N. accesso geni | P06744 |
| Alias gene | Amf; Autocrine motility factor; glucose phosphate isomerase; glucose phosphate isomerase 1; glucose phosphate isomerase 1 complex; glucose phosphate isomerase 1, regulatory; glucose phosphate isomerase 1, structural; glucose phosphate isomerase 1, temporal; glucose-6-phosphate isomerase; glucose-6-phosphate isomerase {ECO:0000250; GNPI; Gpi; GPI {ECO:0000250; gpi {ECO:0000312; GPI1; Gpi-1; Gpi-1r; Gpi1-r; Gpi1s; Gpi-1s; Gpi1-s; Gpi-1t; Gpi1-t; GPI-GlcNAc transferase complex subunit GPI1; hexose monophosphate isomerase; hexosephosphate isomerase; maturation factor; MF; Neuroleukin; neuroleukin {ECO:0000250; NK; NK/GPI; Nlk; NLK {ECO:0000250; Org; oxoisomerase; PGI; PGI {ECO:0000250; Phi; PHI {ECO:0000250; phosphatidylinositol N-acetylglucosaminyltransferase; Phosphatidylinositol N-acetylglucosaminyltransferase subunit GPI1; Phosphoglucose isomerase; phosphoglucose isomerase {ECO:0000250; phosphohexomutase; phosphohexose isomerase; phosphohexose isomerase {ECO:0000250; phosphosaccharomutase; RGD:2727}; SA36; SA-36; sperm antigen; sperm antigen 36; sperm antigen-36; UniProtKB:P06745}; YGR216C |
| Simboli geni | GPI |
| Vedi altri risultati |
Titolo del prodotto
Facendo clic su Invia, l'utente riconosce che potrebbe essere contattato da Fisher Scientific in merito al feedback fornito in questo modulo. Non condivideremo le vostre informazioni per altri scopi. Tutte le informazioni di contatto fornite saranno conservate in conformità con la nostra Politica sulla privacy. Informativa sulla privacy.
Individuate un'opportunità di miglioramento?